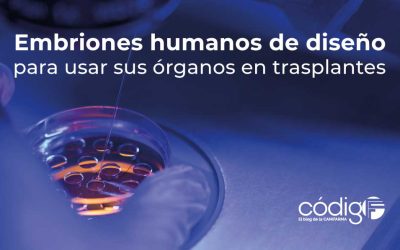
Embriones humanos de diseño para usar sus órganos en trasplantes

1800 millones de adultos en el mundo están en riesgo de morir por falta de actividad física
Las personas mayores de 60 años tienden a ser menos activas que los adultos más jóvenes, lo que hace necesario implementar programas que fomenten la actividad física como un elemento esencial para la salud y el aumento de la expectativa de vida.El estudio sobre la...
Embriones humanos de diseño para usar sus órganos en trasplantes
La controversial iniciativa del biólogo Jacob Hanna se suma a la técnica de edición genética de órganos porcinos como alternativas para abatir a futuro el déficit de partes de reemplazo, planteamientos que encuentran a su paso defensores y detractoresEs probable que...
Un estudio demuestra el efecto positivo de la tirzepatida en el tratamiento de la apnea del sueño
El tratamiento con este fármaco, aprobado por la FDA y la EMA para la diabetes tipo 2 y la obesidad, podría ser una nueva opción para los 1000 millones de personas en todo el mundo que viven con esta condiciónSi usted padece apnea del sueño, conoce de primera mano lo...
Medicamentos formulados con microbiota saludable superan a los antibióticos en el tratamiento de infecciones por C. Difficile
El uso indiscriminado, muchas veces inútil e indolente, de los antibióticos facilitó que las bacterias aprendieran a defenderse de ellos, lo que nos obliga a buscar nuevas alternativas para defendernosEl 12 de mayo del 2023, hace poco más de un año, publicamos que un...
La fundación Novo Nordisk financia un proyecto de investigación binacional, con el que se buscará disminuir el número de muertes prematuras por aterosclerosis
“REACT pretende cambiar los protocolos de prevención cardiovascular mediante la detección de la aterosclerosis a través de un cribado mediante imagen desde edades muy precoces de la vida (20 años) y una intervención personalizada basada en la presencia o ausencia de...
Confirmado: La leche de vacas contagiadas con el virus de la gripe aviar puede infectar a quien la consuma cruda
“Debido a la naturaleza en constante evolución de los virus de la gripe, la OMS sigue destacando la importancia de la vigilancia mundial para detectar y monitorear los cambios virológicos, epidemiológicos y clínicos asociados a los virus de la gripe emergentes o en...